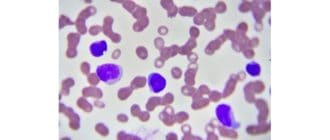

肩の滑液包炎は肩関節の痛みを伴う炎症である。それは一般的で治療可能であり、しばしば数か月以内に治癒する。休息と穏やかな運動は、回復をスピードアップすることができます。 滑液包炎は、滑液包炎の炎症である。嚢は、関節の近くに […]
浮腫は、身体の組織に閉じ込められた余分な液体から生じる腫脹を表す用語です。依存性浮腫は、重力の影響によって引き起こされ、足、脚、または手を含む体の下部に流体が溜まるときに発生します。 この資料では、依存性浮腫の原因と症状 […]
中枢神経系の鬱病は、神経機能が低下すると起こる。これは、物質の過剰摂取、中毒、または他の医学的状態から生じ得る。 中枢神経系(CNS)うつ病は、最も一般的には、脳活動を遅らせる物質の誤用によって生じる。これらの物質は中枢 […]
以前は認知症として知られていた神経認知障害は、脳に影響を及ぼす広範な障害を指す。 すべての神経認知障害(NCD)は、「1つ以上の認知領域における後天性認知低下」を特徴とする。これらの障害は、思考、推論、記憶、および問題解 […]
ダニはヒトに生息する一種の寄生虫です。ほとんどの場合、これらのダニは無害であり、気づかれなくなります。しかし、ダニの数が多いと、望ましくない症状や皮膚の問題を引き起こす可能性があります。 ダニは毛包の中または周囲に生息し […]
ピラール嚢胞は毛包の周囲で成長し、通常は頭皮に現れる。彼らはしばしば無害であり、自分で消えるかもしれません。 嚢胞は、液体で満たされた小さな塊です。それらは皮膚の下に形成される。嚢胞は非常に一般的であり、通常症状や副作用 […]
伝統的な中国医学(TCM)によると、気は常に体の中を循環する重要なエネルギーです。開業医は、気の不足が脾臓と関連しており、休憩して特定の食品を食べると、不均衡を治療できると信じています。 TCMの概念は、現代科学に基づい […]
無作為化比較試験は、新しい医療介入の科学的試験のゴールドスタンダードです。 彼らは、実験的な薬物によってどのレベルの有効性および安全性が達成され得るかを研究する過程において、製薬会社によって満たされなければならない標準と […]
片頭痛を経験する多くの人には、めまいやめまいの感情もあります。これが繰り返し起こると、前庭性片頭痛として知られています。 この状態は、片頭痛に関連するめまいまたはめまい、片頭痛、または片頭痛関連の前庭病とも呼ばれる。 前 […]
粘液嚢胞は、口の中または指およびつま先に発達する傾向のある小さくて液体で満たされた嚢である。彼らは有害ではありませんが、彼らは不快なことがあります。削除するにはいくつかの方法があります。 この記事では、さまざまなタイプの […]
好塩基球増加症は、人の血液中に好塩基球が多すぎる場合を指します。好塩基球は白血球の一種である。 好塩基球増加症はそれ自身の状態ではないが、他の根底にある医学的問題の重要なマーカーとなりうる。 好塩基球とは何ですか? 健康 […]
良性前立腺肥厚は、前立腺が拡大する状態を指す。それは完全に理解されていない理由のために、年を取るにつれて男に起こることがあります。拡大した前立腺は、尿道から尿を遮断したり、遅らせる可能性があります。 良性前立腺肥大(BP […]
小麦アレルギーを患っている人は、小麦に存在する少なくとも1つのタンパク質に異常な免疫応答を示します。 小麦に暴露すると、呼吸困難、悪心、蕁麻疹、肥大した胃、および集中できないことがあります。一部の人々では、アナフィラキシ […]
膣の袖口は、膣の上部に作られた閉鎖部で、子宮頸管は通常どこに位置しています。外科医は、通常は全部または根治的な子宮摘出術の一部として、膣の上部を一緒に縫合することによって膣カフを形成する。 医師は、子宮の外科的除去から利 […]
ヘリオトロープ発疹は、まぶたの周囲または周囲に赤い紫色の発疹があります。発疹は斑状で不均一に見え、しばしば腫れたまぶたを伴う。 ヘリオトロープ発疹は、皮膚筋炎と呼ばれる炎症性筋疾患の最初の顕著な症状として起こる赤紫色の発 […]
人の心は、時計の秒針のように、一定の間隔で鼓動するはずです。不整脈は、心臓のリズムに問題があるとき、または不規則に鼓動するときである。洞性不整脈は不整脈の一種である。 この記事では、副鼻腔不整脈が何であるか、それがどのよ […]
静脈瘤は静脈瘤に類似しているが、脚よりむしろ睾丸の周りに発生する。彼らは通常、深刻な問題を引き起こすことはありませんが、男性の繁殖力に影響を与える可能性があります。 彼らは、血液をポンプで運ぶことに関与する弁のいくつかの […]
花粉症はアレルギー性鼻炎としても知られています。これは、自然のアレルゲンが反応を引き起こし、寒さのような症状を引き起こす場合に発生します。かゆみ、乾燥、持続性の咳が含まれます。 高熱は広範囲に及んでおり、推定40〜60百 […]
骨折は、骨の連続性が損なわれる病状である。 骨折のかなりの割合は、大きな力の衝撃またはストレスのために生じる。 しかし、骨折は、骨粗鬆症、いくつかの癌、または骨形成不全(脆性骨疾患としても知られる)など、骨を弱めるいくつ […]
棘状ヘルニアは、2つの群の腹筋を分離する棘状筋膜または組織の層を通るヘルニアである。筋肉は直筋と呼ばれ、横方向の角膜と呼ばれます。 このタイプのヘルニアは、時々外側腹部ヘルニアとも呼ばれます。ほとんどのヘルニアとは異なり […]
酵母は真菌の一種です。私たちはそれを焼き菓子に使用し、ビールのようなアルコール飲料を作る。酵母にアレルギーのある人は、その成分を含む食品を避けるべきです。 真菌にアレルギーのある人は、カビが菌類に属するので、カビを避ける […]